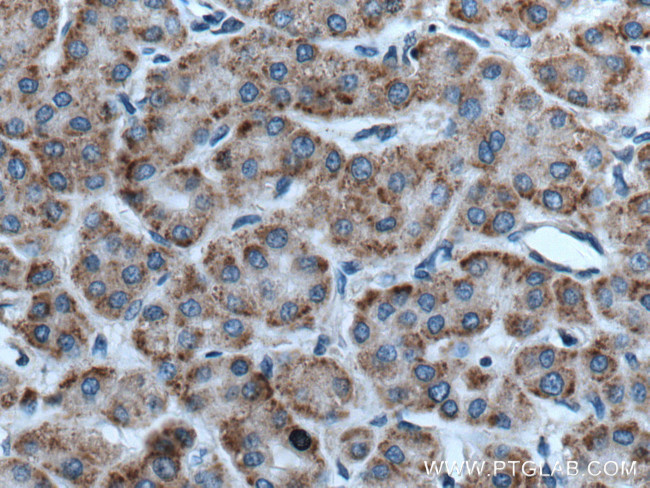
RACK1/GNB2L1 Antibody in Immunohistochemistry (Paraffin) (IHC (P))

Search
Proteintech
RACK1/GNB2L1 Polyclonal Antibody
{{$productOrderCtrl.translations['antibody.pdp.commerceCard.promotion.promotions']}}
{{$productOrderCtrl.translations['antibody.pdp.commerceCard.promotion.viewpromo']}}
{{$productOrderCtrl.translations['antibody.pdp.commerceCard.promotion.promocode']}}: {{promo.promoCode}} {{promo.promoTitle}} {{promo.promoDescription}}. {{$productOrderCtrl.translations['antibody.pdp.commerceCard.promotion.learnmore']}}
产品信息
27592-1-AP
种属反应
宿主/亚型
分类
类型
抗原
偶联物
形式
浓度
规格
纯化类型
保存液
内含物
保存条件
运输条件
产品详细信息
Immunogen sequence: LWNTLGVCK YTVQDESHSE WVSCVRFSPN SSNPIIVSCG WDKLVKVWNL ANCKLKTNHI GHTGYLNTVT VSPDGSLCAS GGKDGQAMLW DLNEGKHLYT LDGGDIINAL CFSPNRYWLC AATGPSIKIW DLEGKIIVDE LKQEVISTSS KAEPPQCTSL AWSADGQTLF AGYTDNLVRV WQVTIGTR (131-317 aa encoded by BC019093)
靶标信息
RACK1 (receptor for activated C kinase 1) was identified through its binding to various PKC isoforms. Its main function is to recruit PKC and various other proteins to specific locations to form multiprotein complexes, mediating various signal pathways. RACK1 is required for VANGL2 membrane localization and for PTK2/FAK1 phosphorylation and dephosphorylation.
仅用于科研。不用于诊断过程。未经明确授权不得转售。
生物信息学
蛋白别名: 12-3; activated protein kinase C receptor; Cell proliferation-inducing gene 21 protein; GNB2L1; guanine nucleotide binding protein (G protein) beta polypeptide 2-like 1; guanine nucleotide binding protein (G protein), beta polypeptide 2 like 1 sequence 1; guanine nucleotide binding protein (G protein), beta polypeptide 2-like 1; guanine nucleotide binding protein beta polypeptide 2-like 1; guanine nucleotide binding protein related; guanine nucleotide binding protein, beta 2, related sequence 1; guanine nucleotide binding protein, beta polypeptide 2-like 1; guanine nucleotide binding protein, beta-2, related sequence 1; Guanine nucleotide-binding protein subunit beta-2-like 1; Guanine nucleotide-binding protein subunit beta-like protein 12.3; HLC-7; Human lung cancer oncogene 7 protein; lung cancer oncogene 7; OTTHUMP00000223870; OTTHUMP00000223891; OTTHUMP00000223893; OTTHUMP00000223900; OTTHUMP00000223901; OTTHUMP00000223902; OTTHUMP00000223930; OTTHUMP00000223931; p205; PIG21; proliferation-inducing gene 21; protein homologous to chicken B complex protein, guanine nucleotide binding; protein kinase C receptor; rack-1; Receptor for activated C kinase; Receptor for activated C kinase 1; receptor for activated protein kinase C; Receptor of activated protein C kinase 1; Receptor of activated protein kinase C 1; Small ribosomal subunit protein RACK1; unnamed protein product
基因别名: AL033335; GB-like; Gnb2-rs1; GNB2L1; H12.3; HLC-7; HLC7; p205; PIG21; RACK1
UniProt ID: (Rat) P63245, (Mouse) P68040, (Human) P63244
Entrez Gene ID: (Rat) 83427, (Mouse) 14694, (Human) 10399